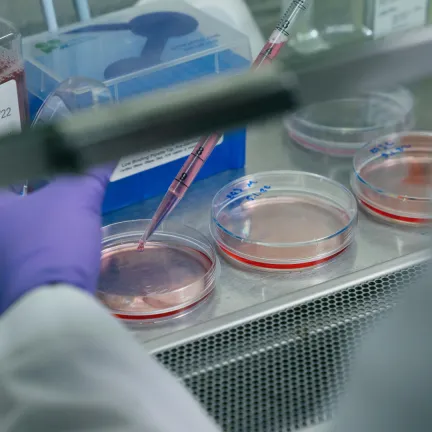
Doing an experiment in the lab.

How do I get involved with research?
Just ask– 40 percent of UVM undergraduates do research with a faculty mentor.
Talk to a faculty mentor in your department Talk to your advisor Consider an internshipOur research experts are your professors
Faculty in the College of Arts and Sciences aren’t just expert teachers—they’re also experts in their fields of study. We have faculty members studying such exciting, wide-ranging topics as whale songs, the link between income and obesity, the connection between doomscrolling and mental health, the influence of climate on forests, race relations in America, and so much more. Here are some other recent highlights.
Discovering the molecular basis of three new blood types–UVM biologist Bryan Ballif, his research team, and international collaborators
- The names of these blood types are Langereis, Junior, and VEL.
- These breakthrough findings have important, life-and-death implications for patients needing blood transfusions.
- Undergraduate students at UVM have the privilege of working directly with Dr. Ballif and his graduate students, either for credit, work study, honors thesis research, and summer internships.
- The Ballif lab primarily uses biochemical, cell biological, and proteomic methods to study the work of proteins not only in blood types, but also in cancer and neuronal development.
- Many undergraduates who have pursued research with Dr. Ballif have gone on to publish articles in prestigious scientific journals, to work in research labs, and to be accepted into highly reputable graduate/professional programs.
"The science of blood transfusion has been attempting personalized medicine since its inception," Ballif notes, "given that its goal is to personalize a transfusion by making the best match possible between donor and recipient. Identifying and making available rare blood types such as Vel-negative blood brings us closer to a goal of personalized medicine."
Researching immigrant populations in Vermont and issues of food security–UVM geography professor Pablo Bose and anthropologist Teresa Mares
- How do immigrant groups maintain their cultural identity through the foods they grow and eat?
- For two years, Mares has been participating in a food security project called Huertas, which means “gardens” in Spanish, helping Latino migrant workers to develop their own kitchen gardens where they can grow vegetables and herbs that are familiar to them.
- The project works in Franklin County and central Vermont with some of the estimated 1,200 to 1,500 Latino migrant workers on Vermont dairy farms.
- Bose studies the ways that refugees maintain cultural ties when they resettle in small and mid-sized towns.
- For over 15 years, Bose has studied the New Farms for New Americans program, which connects Burlington-area immigrants with land and agricultural knowledge and equips them to grow crops that are culturally familiar.
“It helps to build bridges and build relationships between different people in the community, between different people involved in agriculture,” Bose said, and Mares agrees that both research projects illustrate that food security is about more than just nutrition.
Learning more about the families and children of prisoners in Vermont–UVM sociologists Alice Fothergill and Kathy Fox
- Fothergill started the process in her Service Learning Internship seminar, which typically has students work 10-15 hours per week at a local non-profit agency or organization.
- Fox continued the evaluation the following semester in her Criminal Justice Seminar, resulting in interviewing 379 inmates (25 percent of the Vermont’s total in-state prison population) at Vermont’s seven correctional facilities.
- Results from the 90-plus-question survey were tabulated by students in Sociology Professor Jennifer Strickler’s Fundamentals of Social Research course for analysis by Fox’s 18 students.
- Students said they were eager to analyze the data and come up with policy recommendations they could present to the Vermont Department of Corrections executive team and to the Agency of Human Services director of integrated family services.
“As a teacher, seeing students taking ownership and doing service to the state has made this one of the most rewarding experiences in my 20 years of teaching,” Fox says. “My students love the idea that the results of their work might inform policy that could help these individuals. I think we’ll make a difference.”
Student research opportunities abound
Students throughout the College of Arts and Sciences choose to deepen their learning through research. They’re asking questions, making discoveries, and broadening their thinking. These students did—and you can, too.
Rachel Mellen, zoology major, investigated mating habits of a species of ants
Veromessor pergandei are ants that, unusually, form three kinds of colonies: single-queen colonies, colonies with multiple queens, and colonies that temporarily are home to multiple queens but then aggressively compete until a single queen remains. And her work, which involved genetically testing more than 1,000 ants, helped contribute to and expand on the growing evidence that this hypothesis is correct. “The solitary males did mate with more queens than the queens that formed groups, which is what I expected to see,” she says.
Anna Schmoker, chemistry major, recipient of prestigious Goldwater Scholarship for her research
Goldwater Scholarships are the premier undergraduate award in the fields of mathematics, the natural sciences, and engineering. Anna was chosen from a competitive field of 1,206 applicants from universities all over the U.S. Anna came to UVM in the fall of 2012 planning to major in nutrition, which was in line with her background as a professional ballet dancer. However, she discovered her love for chemistry during her first semester on campus and jumped into the field, winning many accolades for her work, including the Beckman Scholarship, which funds two summers and one academic year of in-depth research. After graduation, Anna expects to earn a doctorate in analytical chemistry in her quest to become a professor. She hopes to teach the next generation of scientists while conducting research in analytical chemistry with environmental and health applications.
Adam Vidigni, studio art major, his research resulted in Powe. Snowboards, an eco-friendly snowboard company
Adam used his love of snowboarding, his passion for drawing, and a flair for entrepreneurship to create Powe.Snowboards, an eco-friendly snowboard company based in Burlington. Adam partnered with two environmental studies majors in the Rubenstein School of Environment and Natural Resources, and the students envisioned snowboards that would be ecological and environmentally conscious as well as super light, durable, and as earth-friendly as possible. They found a custom builder in Wisconsin who would manufacture the boards from hemp, bamboo, poplar, and bio-resin epoxy to get away from plastics and carbon fiber materials. Adam then created one-of-a-kind, limited-run art designs for the snowboards. By using renewable and sustainable materials, the response from Burlington, VT to Vail, CO and beyond has proven that Adam’s business idea, along with his passion for artwork, has come to fruition on the slopes of Vermont.
Alia Degen, global and regional studies major, explores the social problems that shape the modern world through service
Alia was selected to be in the “Dean’s Signature” Integrated Social Sciences Program (ISSP), one of the four teacher-advisor programs for first-year students in the College of Arts and Sciences. ISSP explores the social problems that shape the modern world from an interdisciplinary perspective. Her service-mindedness has followed her to UVM where she volunteers with FeelGood, whose proceeds from grilled cheese sales in the Davis Center are donated to help end world hunger. She's also working as a program assistant in the Community-University Partnerships and Service-Learning (CUPS) office on campus, whose mission is to align service opportunities with academic pursuits.
Sophia Hoffacker, double major in environmental studies and political science, award-winning environmentalist
Through Hoffacker's internship in UVM’s Office of Sustainability, she organized the first annual Student Advocacy and Leadership Summit, a forum for campus leaders from environmental, social justice, professional development, and residential learning groups. Last year she was awarded the Udall Scholarship, a prestigious, nationally competitive award for sophomores and juniors who are committed to careers related to environmental or Native American issues. Since 2011, Sophia has been active in the Sierra Student Coalition, a national network of high school and college students working to protect the environment. Sophia, who is from the D.C. area, would like to commit her career and future to educating others about the threat of climate change.